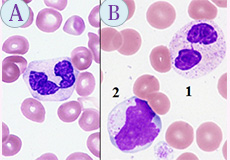

今年のNHK大河ドラマは、「いだてん ~東京オリンピック噺(ばなし)~」(1月6日放送)で幕開けです。数々の挫折を乗り越え、箱根駅伝の創設に携わった“日本マラソンの父”の金栗 四三(かなくりしぞう)」氏の生涯を紹介したものです。
金栗四三氏は、1891年、熊本県春富村(現.和水町)に生まれ、玉名北高等小学校から玉名中学校(現.熊本県立玉名高校)に進学し、特待生に選ばれるほど優秀な生徒でした。毎日往復約12kmの通学路をかけっこで通うことで脚力が鍛えられ、これがマラソンランナーの足固めとなりました。1910年、東京高等師範学校(現.筑波大学)に進学し、当時の校長は、講道館柔道の創始者で日本のオリンピック参加に尽力された嘉納治郎氏でした。嘉納氏は、これらの功績によって“日本の体育の父”と呼ばれるようになりました。
金栗氏は、1911年、国際オリンピック大会選手予選会の25マイル(約40km)マラソンに参加し、当時の世界記録を上回る2時間32分45秒で優勝しました。1912年には日本人初のオリンピック選手としてストックホルム五輪マラソンに出場しましたが、暑さのため26.7キロ付近で棄権し、その申告を怠ったことで現地では“消えたオリンピック走者”と呼ばれたそうです。その後、国内大会では多くの優勝杯を手にし、1924年のパリ五輪にも参加しましたが、32.3キロ付近で意識不明のために棄権し、この大会を最後に陸上競技の第一線から退きました。引退後は、師範学校教師、熊本県初代教育委員長などを歴任し、1962年、玉名市名誉市民として顕彰されました。晩年、玉名市で過ごした金栗氏は、1983年、92歳でその生涯を閉じました。
また、金栗氏は、引退後に東京箱根間往復駅伝競走(箱根駅伝)の開催に尽力し、ご自身の経験から持久力を養う高地トレーニングなど新たな練習法を考案され、世界で戦える若人の育成を図ったようです。尚、マラソンシューズの原型となる靴底にゴムを貼った“金栗足袋”を考案し、実用化しました。
箱根駅伝では、金栗氏が箱根駅伝創立に尽力されたことで、2004年から最優秀選手(MVP)に対して「金栗四三杯」が贈呈されることになりました。今年で95回を迎えた箱根駅伝は、東海大学の総合優勝で幕を閉じ、MVPには八区の区間記録を22年振りに塗り替えた東海大小松陽平(3年)選手が選ばれました。
ところで、“いだてん”は、何を表しているかご存知でしょうか。“いだてん”とは、仏教界において天部に属する神様「韋駄天(いだてん)」を示し、足の速い神様のため、足の速いランナーに対して贈られる称号です。素人なりにも5回のフルマラソンを完走している私ですが、今年も一年間途中棄権のないよう全力で走り続けたいと思います。
形態マガジン号キャプテン 阿南 建一 
今回は、細胞同定と症例検討を提示しました。
細胞同定は、末梢血の形態所見をどのように捉え、正常と異常の境をどこにおいて同定するのかに挑戦します。好中球系と単球系の細胞を提示しました。
症例編は、わずかな臨床像と検査データから次なる検査を模索し、骨髄像から臨床診断を試みて下さい。
末梢血液像の細胞同定を行なって下さい。何か異常所見はありますか。
PB-MG×1000

PB-MG×1000

PB-MG×1000

PB-MG×1000

光顕的所見から臨床診断を考えて下さい。
【所見】
【1~5歳.男性】主訴:貧血、出血傾向
WBC41,500/μL、RBC172万/μL、Hb5.7g/dL、Ht17.1%、PLT1.4万/μL、NCC18.6万/μL
PB-MG×1000

BM-MG×1000

BM-PO/PAS×1000

BM-ACP/A-EST×1000

問題 1
末梢血液像の細胞同定を行なって下さい。何か異常所見はありますか。
【解説】
PB-MG.1000

問題 2
1~5歳.男児。貧血、出血傾向を主訴に来院され、ダウン様の顔貌がみられました。
【解説】
(PB-MG×400)

(BM-MG×1000)

(BM-MG/BM-PO×1000)

(BM-ACP/A-EST×1000)

これから先のページでは、医療関係者の方々を対象に医療機器・体外診断薬等の製品に関する情報を提供しております。当社製品を適正に使用していただくことを目的としており、一部の情報では専門的な用語を使用しております。
一般の方への情報提供を目的としたものではありませんので、ご了承ください。
医療関係者の方は、次のページへお進みください。
(お手数ですが、「進む」ボタンのクリックをお願いします)